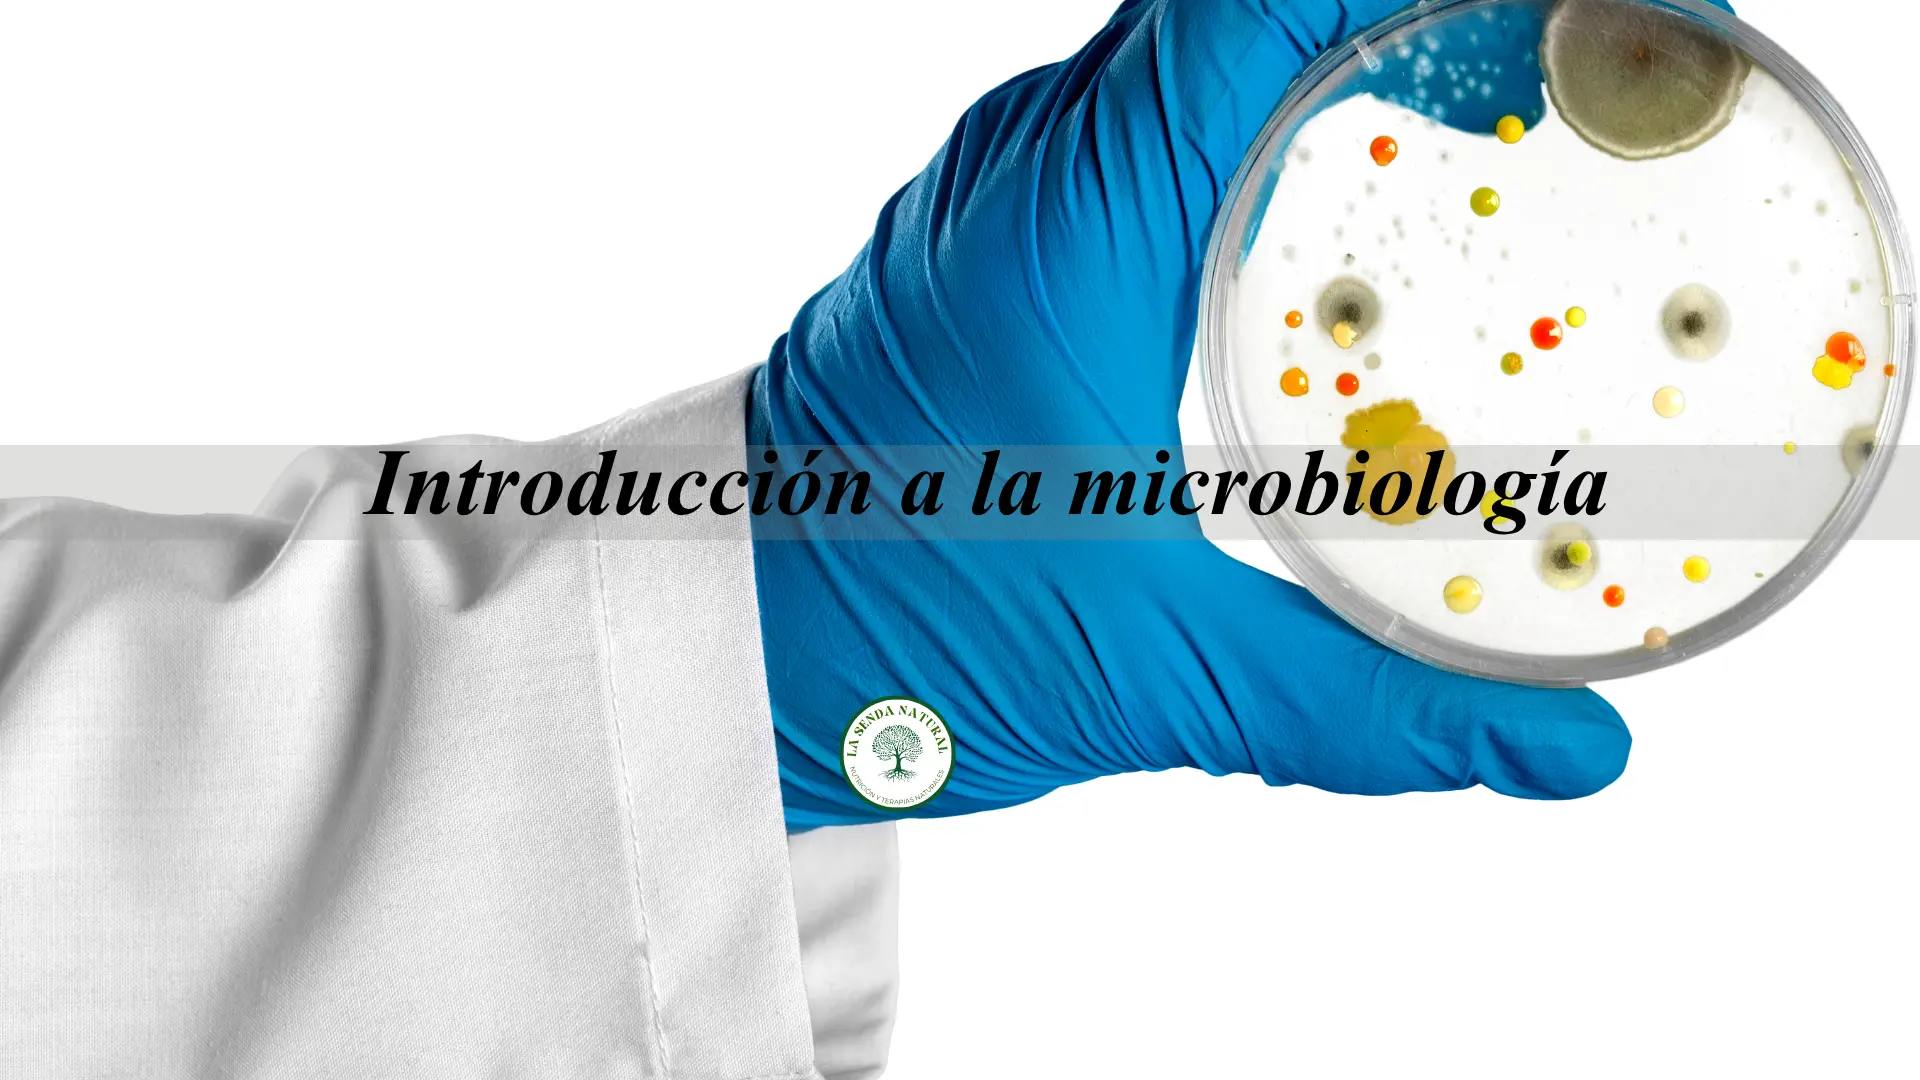
Introducción a la microbiologia

Introducción a la microbiología
(Creado el 15/08/2015, revisado el 22/12/2022, actualizado el 8-04/2026) Introducción a la microbiología: Podemos definir las bacterias como microorganismos unicelulares, con una estructura celular procariota. Las principales diferencias entre las células eucariotas y las procariotas son las siguientes: Las procariotas presentan una pared celular con ácido murámico, mientras que las eucariotas si tienen sólo cuentan […]
Los Parásitos

(Creado el 15/08/2015, revisado el 22/12/2022, actualizado el 8-04/2026) Qué son los Parásitos El término parásito hace referencia a microorganismo que no forman parte del microsistema del huésped y que viven, se alimentan, desarrollan y pueden producir infecciones en algunos casos letales. Los parásitos que pueden ser contraídos al comer determinados alimentos pertenecen a tres […]
Micotoxinas

(Creado el 15/08/2015, revisado el 22/12/2022, actualizado el 8-04/2026) Qué son las micotoxinas y que hacen Cuando diversos hongos se multiplican en los alimentos como resultado de su metabolismo se producen unos compuestos tóxicos, las micotoxinas. Están relacionados con el término contaminación abiótica. La presencia de mohos en el alimento no implica automáticamente la presencia […]
Técnicas de conservación por Frío

Técnicas de conservación por Frío, Esta técnica de conservación de los alimentos se basa en enfriar y mantener los alimentos a temperaturas próximas a los 0ºC (
TECNICAS DE CONSERVACION POR CALOR

(Creado el 15/08/2015, revisado el 22/12/2022, actualizado el 8-04/2026) Técnicas de conservación por Calor Los tratamientos térmicos son procesos que si favorecen especialmente la destrucción o inactivación de enzimas y microorganismos de forma muy efectiva, pero presentan el inconveniente de destruir también nutrientes termolábiles y de acelerar las reacciones no enzimáticas. Para una conservación segura […]
PROCEDIMIENTOS DE CONSERVACION

(Creado el 15/08/2015, revisado el 22/12/2022, actualizado el 8-04/2026) PROCEDIMIENTOS DE CONSERVACION Los procedimientos de conservación tienen como objeto de prolongar la vida de los alimentos, y de almacenar los productos procesados, es absolutamente imprescindible conservarlos de alguna manera, desde un principio se utilizaron ciertas sustancias impermeables como la arcilla o la miel, y más […]
Beneficios de los microorganismos

(Creado el 15/08/2015, revisado el 22/12/2022, actualizado el 8-04/2026) Beneficios de los microorganismos En la industria se hacen a gran escala procesos en muchos casos conocidos desde la antigüedad. A lo largo de la historia, se han podido aislar y conocer con detalle la mayoría de los procesos relacionados con la transformación de los alimentos […]
Virus en los alimentos

(Creado el 15/08/2015, revisado el 22/12/2022, actualizado el 8-04/2026) Cómo actúan los virus en los alimentos Se sabe mucho menos sobre la incidencia de los virus en los alimentos que sobre la incidencia de bacterias y hongos. Los virus son parásitos intracelulares obligados, por lo que no son capaces de replicarse en los alimentos, a […]
Contaminantes ambientales

(Creado el 15/08/2015, revisado el 22/12/2022, actualizado el 8-04/2026) Qué son los metales pesados, donde se encuentran Entendemos por contaminante cualquier sustancia que no haya sido agregada intencionadamente a los alimentos, pero que se encuentra en ellos como residuo de la producción, fabricación, transformación, preparación, tratamiento, empaquetado, transporte o almacenamiento de dicho alimento o como […]
Sustancias anti microbianas

(Creado el 15/08/2015, revisado el 22/12/2022, actualizado el 8-04/2026) Sustancias anti microbianas Algunos alimentos contienen sustancias que poseen actividad antimicrobiana, algunas especies de plantas contienen aceites esenciales con notable poder antimicrobiano. Ejemplo: eugenol en el clavo, la alicina en el ajo, aldehído cinámico y eugenol en la canela, el timol en la salvia, y carvacrol […]